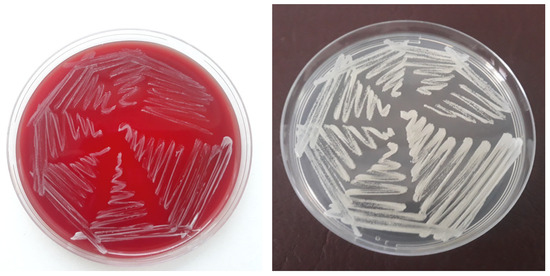

Abstract
Invasive fungal infections are life-threatening conditions that always pose a challenge to veterinary practitioners. The diagnostic and therapeutic approaches in a case of pleural effusion in a domestic cat with a 7-day history of progressive tachypnea were described. Fungal pyothorax was diagnosed on the basis of the clinical signs, radiography findings, complete blood counts, and isolation of the pathogen from pleural effusion samples on two occasions. After three thoracenteses for evacuation of the pleural exudate and 15-day therapy with terbinafine, the general condition of the patient was very good; the complete blood count and respiratory and heart rates returned to normal; and no diagnostic imaging signs of pleural effusion were present. To the best of our knowledge, this is the first report of empyema thoracis caused by Clavispora lusitaniae in a domestic cat. The described case emphasises the primary importance of timely identification of pathogenic agent(s) of feline pyothorax and appropriately prescribed treatment for the prevention of severe complications and fatal outcomes.
1. Introduction
Empyema thoracis is characterised by the accumulation of septic fluid within the pleural space. In cats, the aetiology of the condition often remains non-elucidated. Possible origins of infection include spread from an adjacent structure (bronchopneumonia, parapneumonic spread, oesophageal rupture), direct inoculation (migrating foreign body, penetrating injury, thoracic surgery), or haematogenous/lymphatic dissemination (sepsis) [1].
In most cases, the aetiology of feline pyothorax is associated with co-infection with obligate anaerobes (Clostridium spp., Fusobacterium spp., Bacteroides spp.) and/or facultative aerobes. The prevalence of cases with the participation of Escherichia coli, Salmonella spp., Klebsiella spp., Pseudomonas spp., etc., is less than 20% [2]. Fungal agents of pyothorax in cats are rarely reported and include Cryptococcus spp., Candida albicans, Blastomyces dermatitidis [3,4], and Coccidioides spp. [5].
As stated in a recent review on invasive fungal infections (IFIs) in cats, invasive candidiasis in this species is exceptionally rare, with less than 10 published cases, unlike non-invasive candidiasis of the lower urinary tract, which is more frequent [6]. IFIs may occur in cats of both sexes and at any age. Despite the fact that the disease history usually includes a co-morbidity, they are often diagnosed in apparently immunocompetent cats.
During the last years, the isolation of non-albicans Candida pathogens from invasive fungal infections and empyema, in particular, has increased [7,8]. Among them, Clavispora lusitaniae, formerly known as Candida lusitaniae, is an emerging nosocomial pathogen infecting immunosuppressed patients, and people on continuous antibiotic therapy and cancer chemotherapy [9], but it has also been reported as an agent of empyema thoracis in an immunocompetent patient with acute respiratory distress [10].
For the first time, invasive infection with C. lusitaniae in a cat was reported in a case of peritonitis [11]. The isolate was sensitive to tested antifungal drugs, including amphotericin B, which was attributed to the lack of previous selective pressure and isolation of the agent before the antifungal therapy.
The aim of the present report was to describe the diagnostic and therapeutic approach to the first known case of pyothorax associated with Clavispora lusitaniae in a domestic cat.
2. Case Presentation
A European shorthair cat was referred as an emergency case to the University Veterinary Hospital (UVH), Faculty of Veterinary Medicine, Trakia University, for examination and treatment. The cat was a 3-year-old intact male with a body weight of 3.2 kg. It was kept outdoor in the owners’ house yard, was a very skilled hunter of birds (sparrows), and in the past had been treated several times for bite and scratch wounds during the breeding season. The owners had noticed changes in the cat’s usual behaviour (decreased activity and poor appetite) for about 2–3 weeks. Seven days ago, the cat was brought to a private clinic with mild dyspnoea and cough and was diagnosed with catarrhal pneumonia. A treatment with 12.5 mg/kg amoxicillin–clavulanic acid (Synulox 50 mg palatable tablets, Zoetis, Leatherhead, UK) was prescribed, but despite that, the dyspnoea persisted and had worsened several hours before the referral to the UVH.
The initial physical examination revealed inspiratory dyspnoea, light pink mucous membranes, a capillary refill time (CRT) of 3 s, a rectal temperature of 38.6 °C, lethargy, and anorexia. Lung auscultation detected muffled heart sounds bilaterally (almost undetectable from the left), accelerated bronchovesicular breath sounds, visible rightward cardiac pulsations, tachypnea (67 min−1), and tachycardia (188 min−1). During the examination, no skin wounds were found, but the animal had cicatrices from previous injuries.
After the physical examination, three chest radiographs were taken in the left lateral, right lateral, and dorsoventral views with stationary radiography equipment (Philips, Bucky Diagnost CS4, Amsterdam, The Netherlands), the iQ-CR ACE digitiser system and iQ-VIEW/PRO version 2.7 software. The exposure data were 50 kVp and 10 mAs. The radiographs showed a bilateral pleural effusion with a clear horizontal boundary. The heart, the mediastinum, and the cranioventral and middle lung lobes on the right lateral view were obscured by the collected fluid. The left lateral view visualised a retraction of the lung lobes away from the dorsal chest wall, radiopaque interlobar fissure lines, rounding of lung margins, and moderate atelectasis. On the dorsoventral view, the trachea was displaced to the right side, and the left lung lobes were obscured by the exudate (Figure 1).

Figure 1.
Right lateral (RL), left lateral (LL), and dorsoventral (DV) radiographs of the patient before the thoracentesis, demonstrating accumulated fluid (arrows; RL view), retraction of the lung lobes (black arrowheads, LL and DV views), pleural fissure lines (arrows, LL and DV views), and displacement of the trachea (orange arrowheads, DV view).
Immediately after the radiography, the cat was anaesthetised with propofol (Propofol Fresenius®, Fresenius Kabi GmbH, Bad Homburg, Germany) at a dose of 15 mg/kg, applied intravenously. Fluid therapy included Ringer lactate (Ringer Braun, B. Braun Melsungen AG, Germany) at a flow rate of 10 mL/kg/hour. Bilateral thoracentesis was performed with a peripheral venous catheter and three-way stop cock (Figure 2). On the right side, the thoracentesis was made in the 6th–7th intercostal space, but only a small amount of fluid was removed. On the left side in the 8th intercostal space, 210 mL of opaque milky blood-tinged pleural fluid was evacuated. The fluid was odourless and viscous and contained flocculent matter.

Figure 2.
Evacuation of pleural fluid from the left-side 8th intercostal space (left) and gross appearance of the exudate (right).
Following the thoracentesis, the lateral radiography was repeated to evaluate the results after pleural fluid evacuation (Figure S1). Some fluid was still present in the cranioventral part of the chest, but the visualisation of organs was significantly improved. The cardiac silhouette was already visible, and the lung borders were more distinct.
The rapid blood tests for feline leukaemia virus (FeLV) and feline immunodeficiency virus (FIV) were negative. A blood sample was collected from the cephalic vein for complete blood count (CBC) and biochemical analysis. The results showed leukocytosis with total leukocyte counts of 46.47 G/L [reference range 5.5–19.5 G/L] and neutrophilia of 41 G/L [reference range 2.5–12.9 G/L]. The deviations in biochemical parameters included increased creatine kinase activity—2554 U/L [reference range 70–160 U/L]; increased serum total protein—84.4 g/L [reference range 57–80 g/L]; and increased globulins—52 g/L [reference range 28–45 g/L].
Smears of the pleural fluid were prepared for cytological examination and stained with May–Grünwald Giemsa. The cytology showed predomination of lymphocytes of 5–10 μm in diameter. A large part of these cells had irregular nuclei, possibly due to their long stay in the exudate into the thorax. Neutrophils and macrophages were also visible (Figure 3).

Figure 3.
Cytological smear from the pleural fluid demonstrating lymphocytes, degenerated neutrophils (arrows), and macrophages (arrowheads). May–Grünwald Giemsa staining; scale bar 100 μm (left) and 10 μm (right).
A different antibiotic—clindamycin (Clindavet 75 mg, Provet, Attiki, Greece) at a dose of 5.5 mg/kg every 12 h for 7 days—was prescribed to replace the amoxicillin/clavulanic acid.
A sample for microbiological examination was drawn in a sterile 2 mL syringe and analysed immediately after submission at the microbiology lab. The exudate sample was inoculated on solid nutrient media: blood agar, McConkey agar, Sabouraud agar with 4% dextrose and 0.05 g/L chloramphenicol, and liquid nutrient media—tryptic soy broth (TSB) and thioglycollate medium at 37 °C.
By the 24th hour of cultivation, there was no visible growth on the solid nutrient media. A TSB sample was subcultured on blood agar. By the 48th hour, barely perceptible small white non-haemolytic colonies appeared on the blood agar plate, together with tiny white colonies on the Sabouraud agar. No growth was detected on the McConkey agar and on the 24 h blood agar subculture. By the 72nd hour, blood agar and Sabouraud dextrose agar plates demonstrated visible growth of numerous round, smooth, white non-confluent colonies (Figure 4). At that time, no growth was detected on McConkey agar, blood agar subculture and the thioglycollate medium. Gram-stained microscopic preparations of separate colonies visualised large rounded Gram-positive yeast cells (Figure 5).
Figure 4.
Growth of the pathogen 48 h after subculturing on blood agar at 37 °C (left) and Sabouraud dextrose agar at 37 °C (right).

Figure 5.
(Left): Gram-stained smear from a 24 h single colony subcultured on blood agar; (Right): enlarged view of rectangular area shows budding Gram-positive yeast cells. Scale bar = 5 μm.
The 72 h cultures on blood agar and Sabouraud agar were subcultured on blood and Sabouraud agar, respectively. After 24 h, the growth on both solid media was weak and barely perceptible, and after 48 h, the growth was visible and more prolific on the Sabouraud dextrose agar.
Three days after the first thoracentesis, the patient was brought in again with tachypnea (56 min−1) and tachycardia (187 min−1) but with a normal rectal temperature (38 °C) and CRT (2 s). The radiography confirmed the presence of fluid by the partial border effacement of the cardiac silhouette (Figure S2), so a second thoracentesis was performed only on the left side in the 8th intercostal space using the same anaesthesia protocol. The evacuated pleural fluid was 160 mL, white, opaque, odourless, and viscous. On the post-thoracentesis radiograph taken for evaluation of the condition of the cat, the heart was better visualised, but some pleural fluid still remained in the cranioventral part of the chest. The blood analysis showed leukocytosis (31.9 G/L; reference range 5.5–19.5 G/L) with neutrophilia (23.7 G/L; reference range 2.5–12.9 G/L), but less severe compared to the first blood tests. The owners were warned about the possibility of repeated pleural fluid accumulation.
On the basis of the preliminary results from the microbiological examination suggesting the involvement of yeasts, treatment with 40 mg/kg terbinafine (Terbinafin 250 mg, Genericon Pharma GmbH, Graz, Austria), half a tablet daily for 15 days, was prescribed. The antifungal therapy was complemented with furosemide (Furosemid 5%, Alfasan, Woerden, Netherlands) at 2.5 mg/kg subcutaneously, clindamycin (Clindavet 75 mg, Provet, Attiki, Greece) at 5.5 mg/kg every 12 h, and Ringer lactate (Ringer Braun, B.Braun Melsungen AG, Germany) at 10 mL/kg per hour.
After the presumptive morphological testing, the isolate was submitted for matrix-assisted laser desorption ionisation–time of flight mass spectrometry (MALDI-TOF MS) identification at the National Center of Infectious and Parasitic Disease (Sofia, Bulgaria). The peaks generated by the Bruker MALDI-TOF MS were matched to reference libraries using the BioTyper software v. 4.1.100 (Bruker Daltonics, Bremen, Germany). The isolate was identified as Clavispora lusitaniae—NCBI:txid36911; best match score 2.27; second best match 2.13, corresponding to highly accurate yeast identification [12].
Three days later, a third left-sided thoracentesis was deemed necessary based on the obscured heart silhouette for the evacuation of 190 mL of milky white fluid. On the follow-up right lateral radiograph, the cardiac silhouette and the precordial space were already visible (Figure S3). After the procedure, the clinical status of the cat was improved. The microbiological examination of the pleural fluid sample from the third thoracentesis was repeated; the direct inoculation isolated only a single colony of the pathogen on the blood agar plate after 48 h incubation.
After the 15-day treatment course, the owners informed us that the patient was active and had regained its appetite. A follow-up examination of the patient was scheduled 15 days after the end of the antifungal treatment. The general condition of the patient was very good, with normal respiratory and heart rates. The blood analysis demonstrated normal total leukocyte (8.21 G/L; reference range 2.5–12.9 G/L) and neutrophil counts (3.06 G/L; reference range 2.5–12.9 G/L), as well as slightly increased eosinophil counts (0.95 G/L; reference range 0–0.8 G/L). Serum creatine kinase was mildly elevated (255 U/L; reference range 70–160 U/L). The blood globulin concentration (43 g/L) was within the reference range (28–45 g/L).
On control lateral radiographs (Figure 6), the cardiac silhouette was already clearly seen. Confined dense focal uniform shadows (atelectasis) were observed in the caudodorsal part of the lungs. The dorsoventral view demonstrated a uniform radiopacity in the area of the costophrenic angle, with retraction of the lung lobe (on the left side). The trachea was not displaced, the heart was visible, and moderate atelectasis was present.

Figure 6.
Right lateral (RL), left lateral (LL), and dorsoventral (DV) radiographs of the patient during the control examination 15 days after the end of antifungal therapy: areas of moderate atelectasis (arrowheads on RL and LL views); uniform radiopacity in the area of the costophrenic angle (black arrows; DV view).
3. Discussion
Pleural effusion is a life-threatening condition with progressive worsening dyspnoea and substantial risk of a fatal outcome [13]. The differential diagnoses of thoracic pleural effusion in cats includes congestive heart failure, pyothorax, chylothorax, neoplasia, feline infectious peritonitis, and trauma [14]. In this case, the definitive diagnosis was pyothorax, as the three criteria for fungal empyema thoracis outlined by Ko et al. [15] were met: (1) isolation of a fungal species from the pleural effusion; (2) significant signs of infection, such as fever and leukocytosis; and (3) isolation of the same fungal agent from pleural effusion on more than one occasion, or from pleural effusion and other specimens.
The septic pleural fluid is usually opaque with flocculent matter, creamy, green-tinged, or sanguineous. In our patient, a chylous effusion was initially suspected, because the fluid was odourless, but this was excluded due to the low triglyceride content (0.4 mmol/L). The lack of odour does not rule out an infectious cause, as 20% of cases of infectious pleuritis, particularly in kittens, are caused by unusual bacterial, fungal, or protozoal pathogens [14].
Pyothorax is a progressive illness. The disease may be present 1–2 weeks to a month before the specific clinical signs appear and the effusion becomes extensive [16]. In the presented patient, the owners had noticed changes in the usual behaviour of the pet (lethargy, decreased appetite) for 2 to 3 weeks, and clinical signs (accelerated breathing and cough) appeared 7 days before the referral.
The underlying cause of pyothorax in cats often remains unknown [1,17]. Penetrating injuries, such as bite wounds, as a cause for pyothorax are supported by the findings that outdoor cats in multi-cat households are commonly affected, but a parapneumonic spread has also been suggested as a frequent cause [4]. In our patient, a visible entrance door of infection was not identified, as it only had cicatrices from past injuries, which may be a possible etiological cause in line with the cited literature data.
The observed changes in blood parameters agree with those that are commonly reported in cats with pyothorax. Leukocytosis, neutrophilia, and monocytosis are the most important reported CBC changes [2]. Mild-to-severe hyperglubulinaemia is also often seen in cats with IFIs [6]. The significantly increased serum creatine kinase activity at referral may be attributed to prolonged anorexia and weight loss. In anorexic cats, Fascetti et al. [18] reported elevated creatine kinase activity from moderate to more than 150,000 IU/L (reference 10–100 IU/L).
The morphology of fungal colonies and microscopy of fungal colony smears are usually sufficient for identification at the genus level. PCR or MALDI-TOF mass spectrometry of cultured fungi are the most reliable methods for definitive identification of the IFI pathogen.
Scarce data are available for the role of C. lusitaniae as a pathogen in animals. As already stated, invasive infection with C. lusitaniae in a cat has been reported only in a peritonitis case [10]. C. lusitaniae was histologically proven in a pneumonic lung sample from a sea turtle [19]. In India, the analysis of swab samples from dogs with confirmed otitis externa demonstrated that the ear skin of one dog was colonised with multiple yeast species, including C. lusitaniae. The same yeast species was isolated from the skin microflora of two other healthy dogs [20].
The most common source of yeast infections is the environment. C. lusitaniae has been isolated from a variety of substrates: water, soil, fruits, and vegetables [21]. Several decades ago, this yeast species was recovered from rock pigeon faeces near Turin, Italy [22], along with C. guilliermondii, C. albicans, C. parapsilosis, and C. rugosa, many of which are considered pathogenic. Another study confirmed pigeons as main reservoir of different yeast species of public health importance and their faeces as an ideal environment of yeast replication. C. albicans was the most frequent isolate from faecal samples collected in public squares (29.4%), followed by C. krusei and C. inconspicua (17.6%). C. lusitaniae, C. glabrata, and C. pelliculosa have been detected only in one public square (5.9%) [23]. Taking into consideration the very large population of pigeons in modern cities, it may be suggested that their faeces are a very probable source of contamination with yeasts for dogs and cats with outdoor access, as was the case with our patient.
So far, no study has investigated the interaction between C. lusitaniae and its host. It could be hypothesised that one possible virulence factor is thermotolerance, as it replicates in hosts with body temperatures that are higher that the optimal for fungal growth [9]. Data from the literature have proven the ability of C. lusitaniae to form biofilm due to its hydrophobic capacity [24,25]. Biofilm formation by Candida spp. is important for adhesion to surfaces, protection of the fungal cells against chemical agents, and particularly for host immunity evasion. Garcia-Perez et al. [26] proposed three basic models to explain the latter phenomenon: (1) immunological silence that “hides” the biofilm from the host immune system, which fails to activate its anti-Candida mechanisms; (2) immune deviation, in which biofilm-produced factors make the immune response ineffective; and (3) immune resistance, comprising the structural or molecular biofilm features that make it resistant to immune clearance, even in the presence of an effective biofilm-induced response.
After the initial referral of the patient to the clinic, the broad-spectrum lincosamide clindamycin was prescribed empirically to control the most commonly encountered agents of feline pyothorax—anaerobes and Gram-positive aerobes (including most Staphylococcus spp. and Streptococcus spp.) [27]. As only a few antifungal medications are licenced for veterinary species, the choice of terbinafine was based mostly on its activity spectrum and the convenient tablet size. Terbinafine has been administered in cats at 30–40 mg/kg orally once a day [28]. It is active against many fungi, including yeasts (for example, Candida, Cryptococcus, Malassezia), as well as dermatophytes. In addition to the fungicidal activity, terbinafine possesses anti-inflammatory action due to its scavenging properties [29]. The duration of antifungal treatment is greater than that of therapy with antibiotics, because of the slow growth rate of fungi and the fungistatic mechanism of action [30]. After the treatment course, the condition of the patient improved, and it remained free of clinical signs for 15 days after stopping the terbinafine.
4. Conclusions
The described case emphasises the primary importance of timely identification of pathogenic agent(s) of feline pyothorax and appropriately prescribed treatment for the prevention of severe complications and fatal outcomes. Although most known invasive fungal infections in cats are not zoonoses, the close bond between humans and pets confers a real risk from direct transmission of emerging yeast species that may cause dangerous fungal infections, especially in immunocompromised people.
Supplementary Materials
The following supporting information can be downloaded at https://www.mdpi.com/article/10.3390/jof11030170/s1: Figure S1: Right lateral radiograph of the patient after the first thoracentesis: improved visualisation of the heart (black arrowheads) and a small amount of pleural fluid (orange arrowheads); Figure S2: Right lateral radiograph of the patient before (left) and after (right) the second thoracentesis; Figure S3: Right lateral radiograph of the patient before (left) and after (right) the third thoracentesis. Following the procedure, the heart and precordial space (arrowheads) were already visible.
Author Contributions
Conceptualisation, R.G. and V.D.; methodology, R.G. and V.D.; investigation, R.G. and V.D.; data curation, R.G. and V.D.; writing—original draft preparation, R.G. and V.D.; writing—manuscript editing, R.G.; supervision, R.G. All authors have read and agreed to the published version of the manuscript.
Funding
This research received no external funding.
Institutional Review Board Statement
The case report was described with the permission of the Manager of the University Veterinary Hospital and patient’s owners. All personal data were handled confidentially.
Informed Consent Statement
The owners of the patient gave their informed consent for the use of the data gathered during the examinations.
Data Availability Statement
Data are contained within the article and Supplementary Materials.
Acknowledgments
The authors express their deep gratitude to Ivan Ivanov from the National Center of Infectious and Parasitic Disease in Sofia, Bulgaria, for the identification of the pathogenic yeast described in this study, as well as to Vladimir Petrov and all colleagues from the University Veterinary Hospital in Stara Zagora, Bulgaria, for their professionalism and support.
Conflicts of Interest
The authors declare no conflicts of interest.
References
- Krämer, F.; Rainer, J.; Bali, M.S. Short- and long-term outcome in cats diagnosed with pyothorax: 47 cases (2009–2018). J. Small Anim. Pract. 2021, 62, 669–676. [Google Scholar] [CrossRef] [PubMed]
- Sim, J.J.; Lau, S.F.; Omar, S.; Watanabe, M.; Aslam, M.W. A retrospective study on bacteriology, clinicopathologic and radiographic features in 28 cats diagnosed with pyothorax. Animals 2021, 11, 2286. [Google Scholar] [CrossRef] [PubMed]
- McCaw, D.; Franklin, R.; Fales, W.; Stockham, S.; Lattimer, J. Pyothorax caused by Candida albicans in a cat. J. Am. Vet. Med. Assoc. 1984, 185, 311–312. [Google Scholar] [CrossRef] [PubMed]
- Barrs, V.R.; Allan, G.S.; Martin, P.; Beatty, J.A.; Malik, R. Feline pyothorax: A retrospective study of 27 cases in Australia. J. Feline Med. Surg. 2005, 7, 211–222. [Google Scholar] [CrossRef]
- Arbona, N.; Butkiewicz, C.D.; Keyes, M.; Shubitz, L.F. Clinical features of cats diagnosed with coccidioidomycosis in Arizona, 2004–2018. J. Feline Med. Surg. 2020, 22, 129–137. [Google Scholar] [CrossRef]
- Barrs, V.R.; Beczkowski, P.M.; Talbot, J.J.; Hobi, S.; Teoh, S.N.; Hernandez Muguiro, D.; Shubitz, L.F.; Sandy, J. Invasive fungal infections and oomycoses in cats: 1. Diagnostic approach. J. Feline Med. Surg. 2024, 26, 1098612X231219696. [Google Scholar] [CrossRef]
- Denning, D.W. Global incidence and mortality of severe fungal disease. Lancet Infect Dis. 2024, 24, e428–e438. [Google Scholar] [CrossRef]
- Iqbal, N.; Ali, A.S.; Zahid, A.; Jabeen, K.; Irfan, M. Fungal empyema thoracis, a rare but an emerging entity: A retrospective case series from Pakistan. Ther. Adv. Infect. Dis. 2024, 11, 20499361231223887. [Google Scholar] [CrossRef]
- Mendoza-Reyes, D.F.; Gómez-Gaviria, M.; Mora-Montes, H.M. Candida lusitaniae: Biology, pathogenicity, virulence factors, diagnosis, and treatment. Infect. Drug Resist. 2022, 15, 5121–5135. [Google Scholar] [CrossRef]
- Haseeb, U.; Rasool, M.; Swaminathan, G.; Hosna, A.U.; Ishfaq., S.; Trandafirescu, T. Candida lusitaniae, an emerging opportunistic pathogen in immunocompetent populations: A case report. Cureus 2023, 15, e43211. [Google Scholar] [CrossRef]
- Amorim, C.F.; Antón, A.R.S.; Portela, R.W. Perfil de sensibilidade a antifúngicos de Candida lusitaniae isolada de caso de peritonite felina. Rev. Ciênc. Méd. Biol. 2023, 22, 480–485. [Google Scholar] [CrossRef]
- Cassagne, C.; Normand, A.C.; L’Ollivier, C.; Ranque, S.; Piarroux, R. Performance of MALDI-TOF MS platforms for fungal identification. Mycoses 2016, 59, 678–690. [Google Scholar] [CrossRef] [PubMed]
- Beatty, J.A.; Barrs, V.R. Pleural effusion in the cat: A practical approach to determining aetiology. J. Feline Med. Surg. 2010, 12, 693–707. [Google Scholar] [CrossRef] [PubMed]
- Barrs, V.R.; Beatty, J.A. Feline pyothorax—New insights into an old problem: Part 1. Aetiopathogenesis and diagnostic investigation. Vet. J. 2009, 179, 163–170. [Google Scholar] [CrossRef]
- Ko, S.C.; Chen, K.Y.; Hsueh, P.R.; Luh, K.T.; Yang, P.C. Fungal empyema thoracis: An emerging clinical entity. Chest 2000, 117, 1672–1678. [Google Scholar] [CrossRef]
- Medardo, M.; Capozza, P.; Bertazzolo, W.; Paltrinieri, S.; Martino, P.A.; Martella, V.; Decaro, N. Diagnosis of septic body cavity effusion in dogs and cats: Cytology vs. bacterial culture. Animals 2024, 14, 1762. [Google Scholar] [CrossRef]
- Johnson, L.R.; Epstein, S.E.; Reagan, K.L. Etiology and effusion characteristics in 29 cats and 60 dogs with pyothorax (2010–2020). J. Vet. Intern. Med. 2023, 37, 1155–1165. [Google Scholar] [CrossRef]
- Fascetti, A.J.; Mauldin, G.E.; Mauldin, G.N. Correlation between serum creatine kinase activities and anorexia in cats. J. Vet. Intern. Med. 1997, 11, 9–13. [Google Scholar] [CrossRef]
- Mastrostefano, A.A.; Frasca, S., Jr.; Stacy, B.A.; Wickes, B.L.; Wiederhold, N.P.; Cañete-Gibas, C.F.; Stacy, N.I.; Beck, S.; Tuxbury, K.A.; Joblon, M.J.; et al. Clinical observations, identification, and antimicrobial susceptibility of fungi isolated from sea turtles with histologically confirmed mycotic infections: 20 cases, 2005–2020. J. Herpetol. Med. Surg. 2024, 34, 53–69. [Google Scholar] [CrossRef]
- Yadav, A.; Wang, Y.; Jain, K.; Panwar, V.A.R.; Kaur, H.; Kasana, V.; Xu, J.; Chowdhary, A. Candida auris in dog ears. J. Fungi 2023, 9, 720. [Google Scholar] [CrossRef]
- Rojas, O.C.; Montoya, A.M.; Treviño-Rangel, R.J. Clavispora lusitaniae: From a saprophytic yeast to an emergent pathogen. Fungal Biol. 2024, 128, 1933–1938. [Google Scholar] [CrossRef] [PubMed]
- Vidotto, V.; Gallo, M.G. Indagine sulla presenza di lieviti nelle feci di colombo torraiuolo (Columba livia Gmelin 1789) provenienti da contesti rurali. Parassitologia 1985, 27, 313–320. [Google Scholar] [PubMed]
- Rosario Medina, I.; Román Fuentes, L.; Batista Arteaga, M.; Real Valcárcel, F.; Acosta Arbelo, F.; Padilla Del Castillo, D.; Déniz Suárez, S.; Ferrer Quintana, O.; Vega Gutiérrez, B.; Silva Sergent, F.; et al. Pigeons and their droppings as reservoirs of Candida and other zoonotic yeasts. Rev. Iberoam. Micol. 2017, 34, 211–214. [Google Scholar] [CrossRef] [PubMed]
- Atkinson, B.J.; Lewis, R.E.; Kontoyiannis, D.P. Candida lusitaniae fungemia in cancer patients: Risk factors for amphotericin B failure and outcome. Sabouraudia 2008, 46, 541–546. [Google Scholar] [CrossRef]
- Angiolella, L.; Rojas, F.; Giammarino, A.; Bellucci, N.; Giusiano, G. Identification of virulence factors in isolates of Candida haemulonii, Candida albicans and Clavispora lusitaniae with low susceptibility and resistance to fluconazole and amphotericin B. Microorganisms 2024, 12, 212. [Google Scholar] [CrossRef]
- Garcia-Perez, J.E.; Mathé, L.; Humblet-Baron, S.; Braem, A.; Lagrou, K.; Van Dijck, P.; Liston, A. A framework for understanding the evasion of host immunity by Candida biofilms. Front. Immunol. 2018, 9, 538. [Google Scholar] [CrossRef]
- Walker, A.L.; Jang, S.S.; Hirsch, D.C. Bacteria associated with pyothorax of dogs and cats: 98 cases (1989–1998). J. Am. Vet. Med. Assoc. 2000, 216, 359–363. [Google Scholar] [CrossRef]
- Kotnik, T.; Kozuh Erzen, N.; Kuzner, J.; Drobnic-Kosorok, M. Terbinafine hydrochloride treatment of Microsporum canis experimentally-induced ringworm in cats. Vet. Microbiol. 2001, 83, 161–168. [Google Scholar] [CrossRef]
- Camera, E.; Cannistraci, C.; Briganti, S.; Colombo, D.; Picardo, M. Scavenging effects of terbinafine on free radicals in vitro. Br. J. Dermatol. 1999, 140, 640–644. [Google Scholar] [CrossRef]
- Renner, K.; Hill, S.; Grinberg, A.; Weeden, A. Pancreatic candidiasis in a cat. J. Feline Med. Surg. Open Rep. 2021, 7, 20551169211052889. [Google Scholar] [CrossRef]
Disclaimer/Publisher’s Note: The statements, opinions and data contained in all publications are solely those of the individual author(s) and contributor(s) and not of MDPI and/or the editor(s). MDPI and/or the editor(s) disclaim responsibility for any injury to people or property resulting from any ideas, methods, instructions or products referred to in the content. |
© 2025 by the authors. Licensee MDPI, Basel, Switzerland. This article is an open access article distributed under the terms and conditions of the Creative Commons Attribution (CC BY) license (https://creativecommons.org/licenses/by/4.0/).